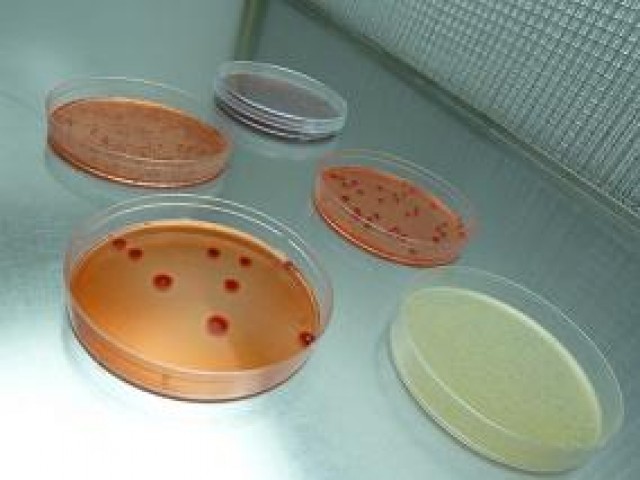
Cultivos puros

-
Robert Hooke descubre las celulas al observar una lamina de corcho, mediante su versión del microscopio (con 2 pares de lentes), en done marca el comienzo de la teoria celular la cual postula que todos los seres vivios estan compuestos por celulas.
-
Van Leeuwenhoek fue el primero en observar los microorganismos vivos a traves de las lentes de aumento con las cuales construyo mas de 400 microscopios
-
Van Leenuwenkoek dibuja los primeros protozoos y bacterias al observar agua de lluvia, sus propias heces y material de raspado de sus dientes.
-
Carolus Linnaeus establecio el sistema de nomenclatura (denominacioón) de los organismos el cual emplea dos nombres: un genero y un epiteto especifico
-
Edward Jenner introdujo la primera vacuna segura contra el virus de la viruela.
-
Agostino Bassi demostro que otra enfermedad del gusano de la seda era producida por un hongo.
-
Anton de bary, conocido como el padre de la fitopatologia y fundador de la micologia al descubrir enfermedades micoticas producidas por hongos y bacterias sobre las plantas
-
Pasteur descubre que los microorganismos llamados levaduras convertian los azucares en alcohol en ausencia de aire.
-
La academia de ciencias desaprueba la teoria de Pasteur.
-
Pasteur soluciona el problema del deterioro al someter la cerveza y el vino a una temperatura suficiente para destruir la mayor parte de bacterias que causaban dicho deterioro.
-
Lister introdujo la tecnica de la desinfeccion con fenol para las heridas quirurgicas, al descubrir que esta practica disminuia las infecciones causadas por microorganismos
-
Koch implementa la teoria germinal de la enfermedad al descubrir la posibilidad de que los microorganimos pudieran tener relacion con los vegetales y con los animales y que estos causaran enfermedad
-
Neisser identifico la bacteria gonococo una enfermedad de transmision sexual que se presenta en los humanos.
-
Robert Koch invento los metodos sobre medios solidos para obtener cultivos bacterianos puros.
-
Finlay Barres aporto descubrimientos importantes sobre la teoria metaxenica del contagio de enfermedades, como el agente transmisor de la fiebre amarilla y su cura.
-
Hess crea el agar como agente solidificante para la observacion ideal de la morfologia macroscopica de las colonia microbianas, mas conocido como la gelatina.
-
Descubierta por Robert Koch quien la describio como una bacteria responsable de la mayor cantidad de casos de tuberculosis en el mundo quien la denomino bacilo de Koch
-
Koch descubre el agente causal de la colera al cultivar y examinar en los intestinos de todos los enfermos de colera la bacteria Vibrio cholerae
-
Theodor Escherich famoso por descubrir la bacteria escherichia coli dedicada a su nombre, la cual es necesaria para el funcionamiento correcto del sistema digestivo.
-
La tinción de gram fue desarrollada por el bacteriologo Hans Gram y es uno de los procesos de tinción mas utiles porque permite calsificar las bacterias en dos grandes grupos: grampositivas y gramnegativas.
-
Elie Metchnikoof padre del concepto general de inmunidad celular, quien con sus investigaciones a los leucocitos de mamiferos y demostro su capacidad de "ingullir" microorganismos mediante un mecanismo que denomino fagocitosis.
-
Julios Richard Petri ayudante del bacteriologo koch quien fabrica las placas de petri para albergar los medios de cultivos bacteriologicos.
-
Kitasato Shibasaburō demostró que el organismo podría producir enfermedad cuando se inyecta en animales, y que la toxina podría ser neutralizado por anticuerpos específicos.
-
Von Behring gano el premio nobel por descubrir la antitoxina difterica con el fin de disponerla para uso terapeutico.
-
Ehrlich creador del compuesto quimico 606 sobre la sifilis para combatir la espiroqueta bacteriana causante de esta enfermedad.
-
Rous peyton patologo e investigador del cancer mas influyentes, Demostro que un agente transmisible podia causar tumores, el agente era un retrovirus, despues denominado virus del sarcoma de Rous
-
Fleming, Florey y Chain ganadores del premio nobel en medicina y fisiologia por el descubirmiento de la penicilina y sus efectos curativos en varias enfermedades infecciosas.
-
Stanley se dedico a aislar el virus en la forma mas pura y concentrada que le fue posible, recurriendo a las tecnicas de separacion de proteinas y es asi como obtuvo el virus en forma cristalina, lo cual compartio el premio nobel con Sumner y Northrop mas conocidos como los cristalizadores de enzimas
-
Delbrück y colaboradores, sistematizaron los análisis genéticos en fagos que infectaban a la bacteria E. coli. Max Delbrück y Salvador Luria recibieron el Premio Nobel en 1969 por sus estudios con fagos.
-
La primera evidencia del papel del DNA en la herencia fue aportada por Avery. Mcleod y Mccarty lo cual descubirieron que exista la posibilidad de que el agente transmisor de la herencia fuera el contenido proteico del acido necleico obtenido de una capa virulenta del streptoccoco.
Plan projects on a visual timeline
Map milestones, phases, deadlines, and key events in one place so the sequence is easier to see and share. Timetoast is a timeline maker for work, school, research, and stories.